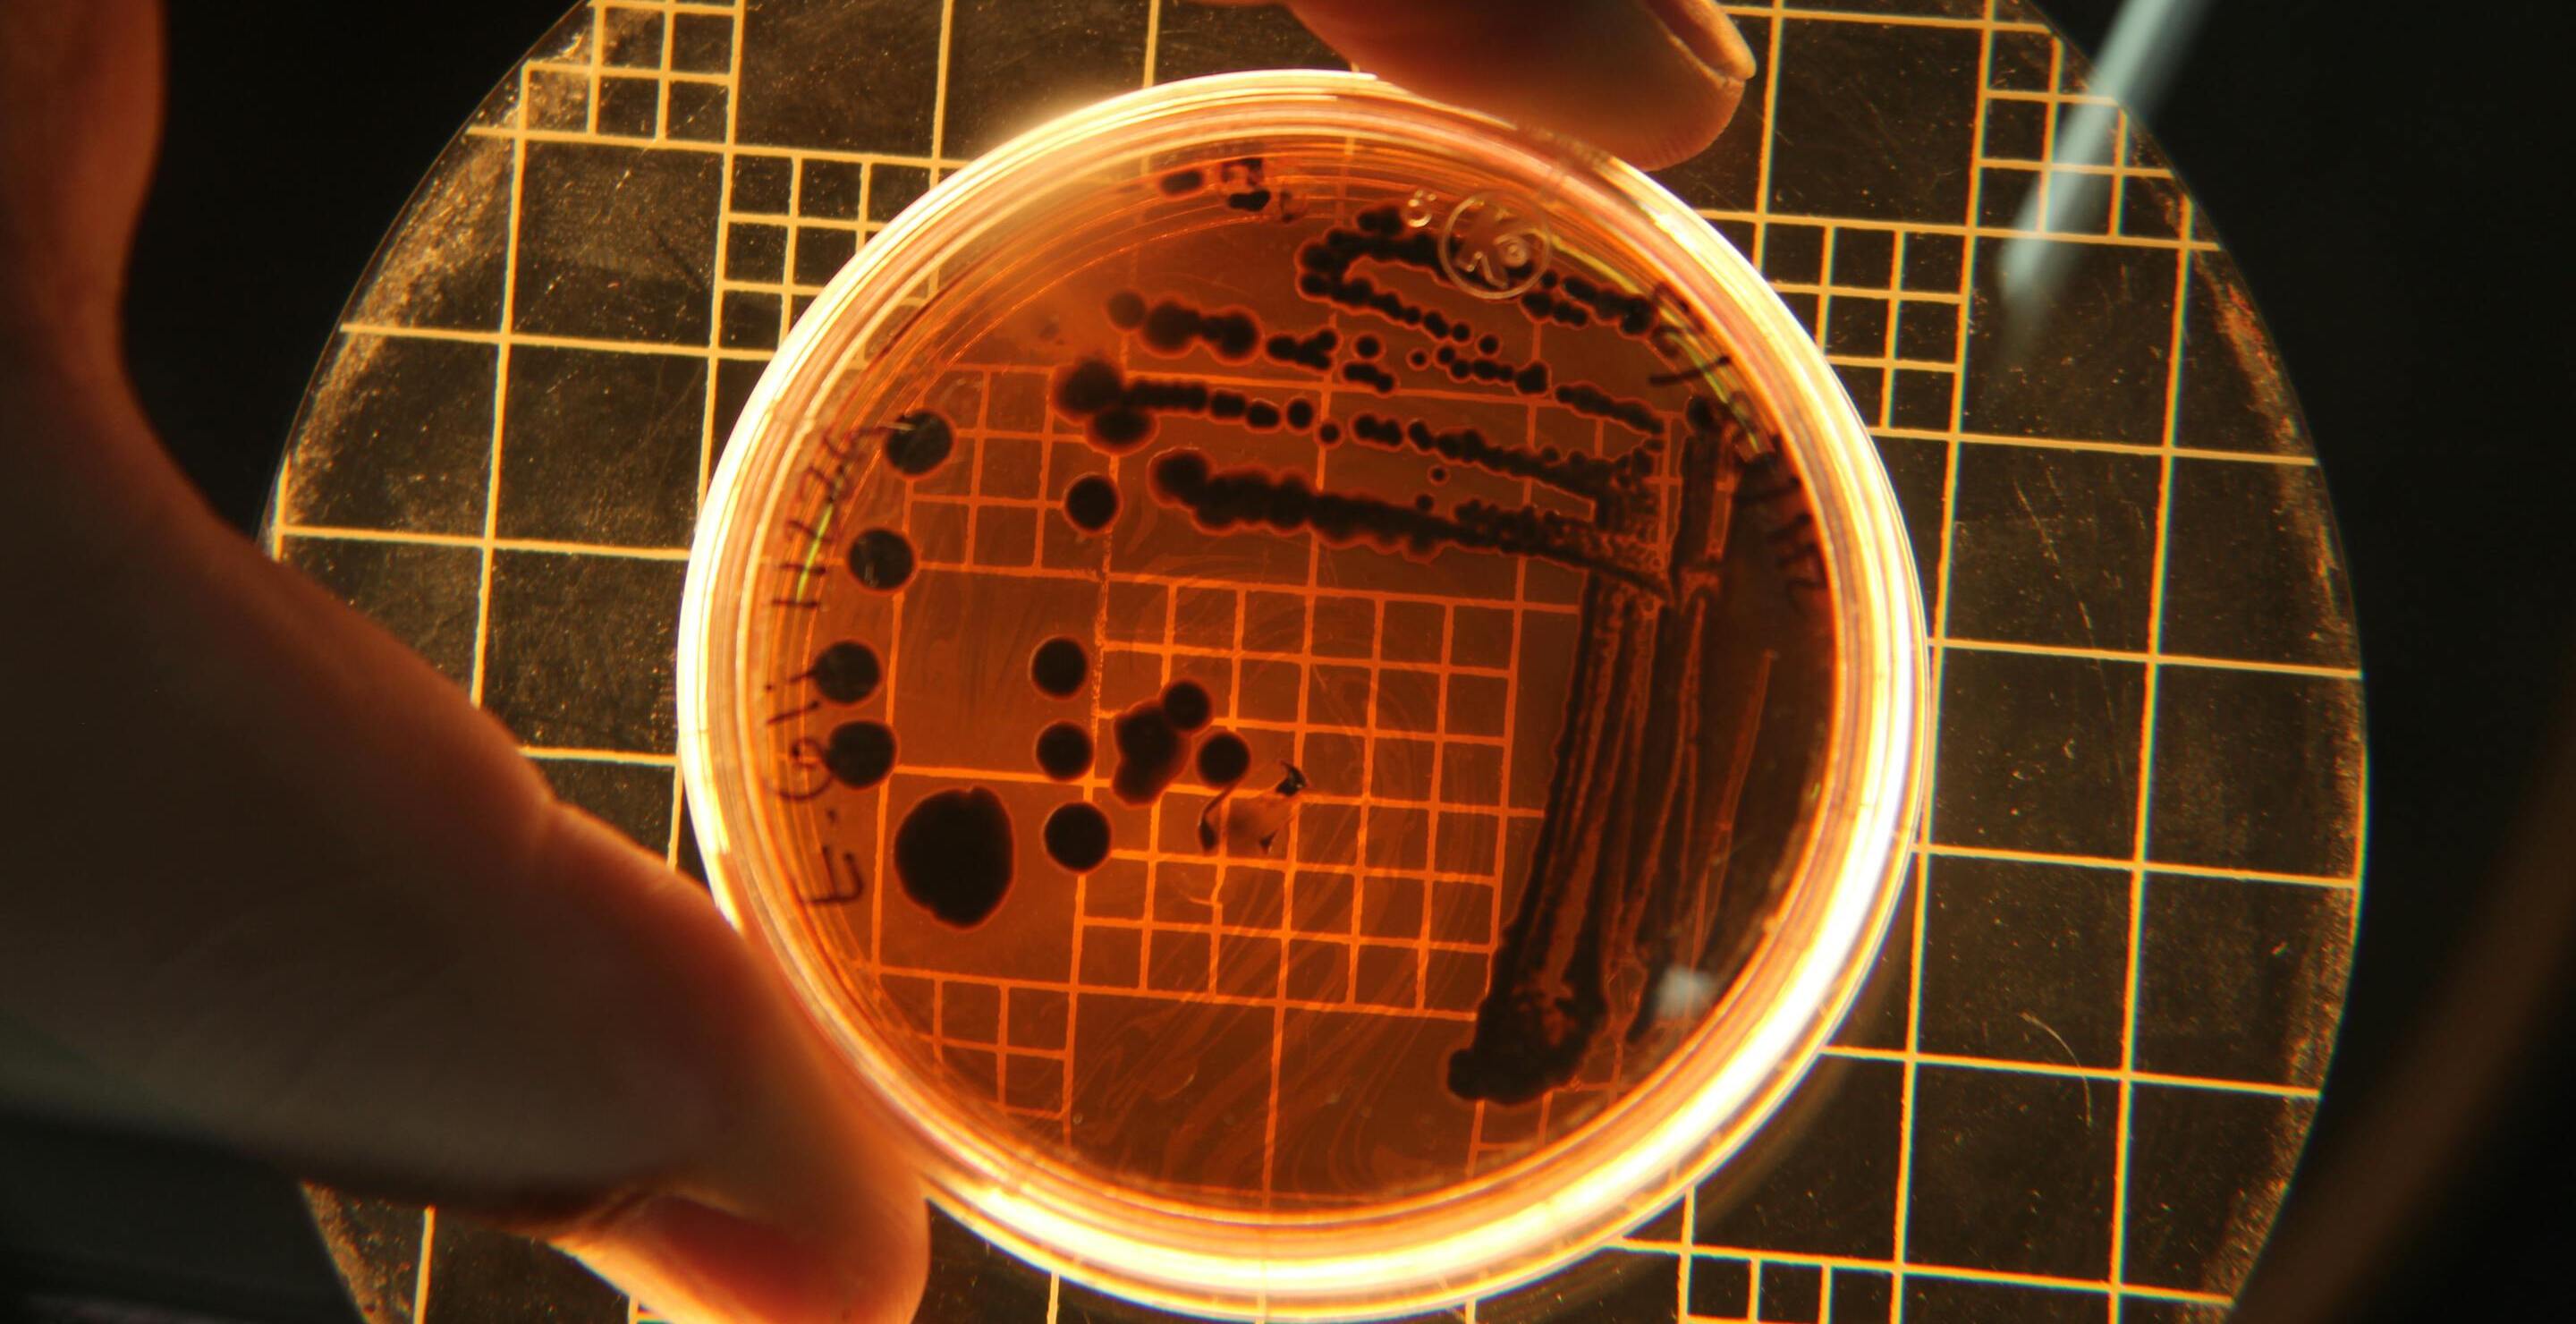

In some rare cases, an untreated STD can develop from an annoying itch or burn to something much more severe, causing serious complications, including death. After a woman in Alaska recently died from a rare strain of gonorrhea, doctors are urging people to get tested.
The 50-year-old woman had been complaining of respiratory problems before her death from the rampant STD in her body. She was found to be suffering from septic shock and heart failure.
Multiple tests were run on the woman, and she was diagnosed with the Neisseria gonorrhoea bacterium. It had spread to various places around her body after making its way into her bloodstream. This developed into disseminated gonococcal infection, which destroyed her health.
She eventually lost her life due to the long-unattended STD in her body. For months, she had been suffering from the rare but eventually fatal strain of gonorrhea. The particular strain is rare, but when left untreated can result in bacteremia, meningitis, and endocarditis.
Alaska Residents Warned to Get Checked For Fatal STD
The unnamed woman who died from the undiagnosed STD was a rare case, but she had been suffering for some time. Despite having at least two visits from healthcare professionals in the past, the woman had not undergone any GC testing.
She had been repeatedly visited due to her opioid use. It is expected that during these visits, she had already been infected. However, by the time she was admitted to the hospital, it was already too widespread, and too much of her body was affected.
A bulletin posted in the Alaska region is encouraging people to visit their local clinic and get tested for gonorrhea and other possible STDs. People with multiple partners, or people with a new sexual partner, should remain especially alert to the situation.
In the Anchorage area alone, five women have been diagnosed with DGI. None of the women had a verifiable link, suggesting that there may be multiple sources of the deadly STD. Some of the possible telltale signs are listed as fever or chills, swelling of the joints, and pain in the tendons of the wrists or heels.